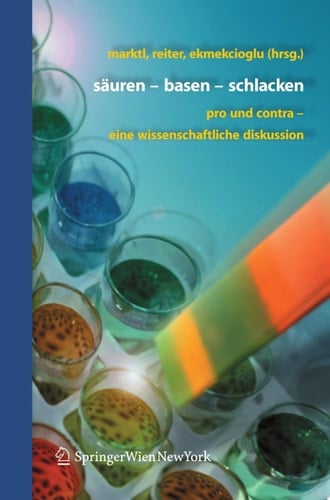
Säuren - Basen - Schlacken

Entschlackungskuren haben Hochsaison, besonders im Frühling. Sie entsprechen unserem Bedürfnis mobil, fit und gesund zu sein. Doch was sind "Schlacken"? Es sind nicht verstoffwechselte Produkte, die im menschlichen Körper verbleiben und dessen Funktionstüchtigkeit beeinträchtigen sollen. Die Schulmedizin wendet hierzu ein, dass Schlacken nicht nachweisbar seien. Und was meint die Naturheilkunde? Ebenso umstritten ist das Thema der Balance aus Säuren und Basen. Obwohl es keine pathophysiologisch nachweisbare "Übersäurung" gibt, sind Produkte und Therapien, die den Körper mit "Basen" versorgen, sehr gefragt. Namhafte Experten diskutieren wertfrei Pro und Contra.
Page Count:
170
Publication Date:
2007-07-28
ISBN-10:
3211693734
ISBN-13:
9783211693735
No comments yet. Be the first to share your thoughts!